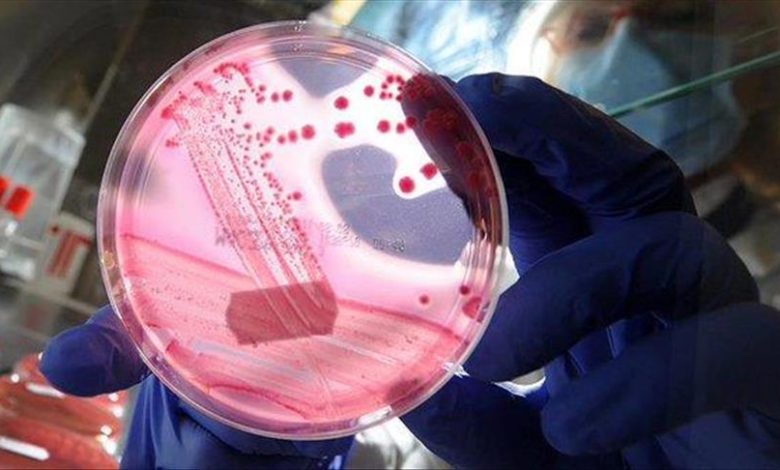
ABD7F0E9 6FCE 4A36 A706 4C3B3816F42F

الصحة تعلن تسجيل حالات اصابة ووفاة بـ “الحمى النزفية”
أعلنت وزارة الصحة تسجيل حالات إصابة ووفيات بمرض “الحمى النزفية” الذي ينتقل من الحيوان إلى الإنسان ولا يوجد علاج او لقاح له لغاية الان.
وقال مدير تعزيز الصحة في الوزارة هيثم العبيدي للصحيفة الرسمية وتابعته (الاولى نيوز)، (17 تموز 2021)، “نظرا لاقتراب عيد الأضحى المبارك، فيتوجب أخذ الحيطة والحذر من مرض الحمى النزفية الفيروسية الخطير، كونه معديا اذ ينتقل من الماشية المصابة الى الانسان، ويسبب اعراضا شديدة ونزيفا، واخيرا الوفاة بنسبة تبلغ 60 بالمئة”.
وأضاف أن “الفيروس ينتشر عن طريق مخالطة الحيوانات المصابة، أو لدغات البعوض أو القراد الذي يتكاثر على جلدها، او من يقوم بذبحها بسبب عدم استخدامه للكفوف او الملابس والنظارات، أو عن طريق دم الاضاحي من خلال جروح اصيب بها الانسان، او التعرض لدم مصاب أو سوائل الجسم الأخرى”، مبيناً أن الفيروس “ينتشر لاحقا من إنسان إلى آخر بملامسة دمه أو أعضائه أو سوائل جسمه الأخرى”.
وتابع العبيدي، أن “أعراض المرض الذي تبلغ مدة حضانته أسبوعين، تبدأ بشكل مشابه للإنفلونزا وتظهر منذ الأسبوع الأول، وهي حمى شديدة، وصداع وإسهال وغثيان وقيء، وآلام بالعضلات والعظام والمفاصل، فيما يكون الأسبوع الثاني هو الأخطر إذ يحدث نزيف بجميع مناطق الجسم ويظهر بالقيء والإسهال الدموي، ليستمر عشرة أيام تحدث الوفاة خلالها”، مؤكدا “عدم وجود أي علاج أو لقاح محدد لهذا المرض الفيروسي حتى الآن”.
ودعا العبيدي، الملاكات الطبية من المتعاملين مع مصابي حمى الفيروس، ألى “الالتزام بارتداء القفازات وواقيات العينين والوجه الشبيهة بملابس الوقاية من جائحة كورونا، عند التعامل مع الدم أو سوائل الجسم، مع الحذر عند التعامل مع عينات المختبرات والنفايات وتطهيرها والتخلص منها فوراً”.
ويشار الى ان التحذيرات جاءت بعد ان سجلت البلاد خلال الأسبوعين الماضيين، ثلاث وفيات، واحدة ببغداد، إضافة إلى اثنتين في ذي قار، مع حالتين مشتبه بهما في الأنبار.




